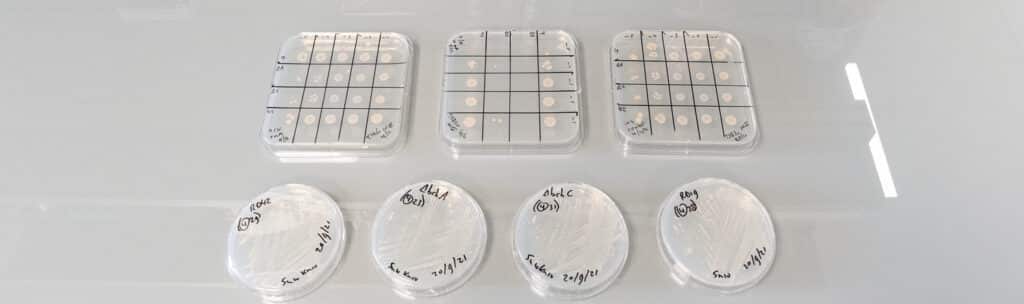

Quand l’oxygène prime sur le sucre : une autre histoire de la photosymbiose

Une équipe du BIAM, en collaboration avec le Laboratoire de Chimie Bactérienne (LCB), propose un nouveau scénario pour l’origine des photosymbioses. Leurs travaux suggèrent que l’oxygène produit par la photosynthèse, et non les sucres, peut constituer l’avantage initial de ces associations qui ont profondément transformé la biosphère. Les photosymbioses, ces associations intimes entre un organisme […]
Interview – Lauréate du Prix Jeunes Chercheuses

Explorer le potentiel des bactéries magnétotactiques pour la médecine de demain Lauréate du Prix Jeunes Chercheuses décerné par la Métropole Aix-Marseille-Provence, Lucia Gandarias-Albaina, post-doctorante au sein du BIAM, voit ses travaux récompensés pour leur originalité et leur potentiel applicatif. À la croisée de la microbiologie, de la biotechnologie et des sciences des matériaux, ses recherches […]
IrrE, l’enzyme de survie des bactéries radiotolérantes Deinococcus,
entre dans le panthéon des peptidases
Après vingt ans de recherches sur les bactéries Deinococcus, réputées pour leur résistance exceptionnelle aux radiations et à la dessiccation, le BIAM célèbre une reconnaissance internationale : l’enzyme IrrE, régulateur indispensable à la survie cellulaire après des stress intenses, fait son entrée dans l’ouvrage de référence mondial sur les peptidases. Cette distinction met en lumière […]
MTBiocare – Grand Prix i PhD

Quand la biotechnologie réinvente le diagnostic et le traitement du cancer Chaque année, le Grand Prix i‑PhD récompense des jeunes scientifiques dont les innovations peuvent devenir des start-ups à fort impact. Cette année, Sandy Payan, ingénieure au BIAM, est lauréate du concours pour MTBiocare, une technologie de nanoparticules de fer capable de transformer le diagnostic […]
Éveiller les jeunes aux sciences et aux enjeux environnementaux :

Cordée de la Réussite du BIAM Donner vie aux découvertes scientifiques du BIAM dans les écoles et éveiller les jeunes aux enjeux environnementaux : après une première édition couronnée de succès, la Cordée de la Réussite du BIAM revient pour 2025-2026. Au programme : des projets concrets mêlant élèves, enseignants et chercheurs, pour expérimenter, apprendre […]
Des bactéries alliées de la reforestation face à la sécheresse

Face à l’augmentation et à l’intensification des épisodes de sécheresse menaçant les jeunes arbres, le BIAM participe au projet RESTORE qui propose une approche bio-inspirée et écologique pour renforcer la résistance des forêts. Sa solution ? Des communautés bactériennes sur-mesure, sélectionnées dans des sols partiellement privés de pluie, pour soutenir la croissance et la survie […]
Cycle du carbone océanique

les microalgues dévoilent un équilibre inattendu entre photosynthèse et photorespiration Communiqué de presse Une équipe internationale dirigée par le BIAM (CEA-CNRS-Aix-Marseille Université) révèle que deux processus clés du métabolisme des microalgues – la concentration du CO₂ et la photorespiration – ne s’excluent pas, mais au contraire coopèrent. Cette découverte, publiée ce mois-ci dans les pages […]
Science et image

Une après-midi pour décrypter les images scientifiques avec leurs auteurs #104Paris/5 avril 2025/ 15h30-19h Comment l’image façonne-t-elle notre perception du monde ? Dans le cadre d’un événement organisé par le CEA et le CENTQUATRE-PARIS, une scientifique du BIAM présentera « Les plantes de demain face aux défis climatiques ». Elle explorera le rôle essentiel de l’imagerie de […]
Bioénergie : La production d’huile par les microalgues vient d’être quintuplée !

En désactivant un frein naturel à la synthèse des acides gras, les chercheurs du BIAM ont réussi à multiplier par cinq la teneur en huile des microalgues. Une avancée considérable pour l’optimisation des bioénergies, qui ouvre la voie à une plus grande efficacité de production durable. Les acides gras jouent un rôle essentiels dans la […]
Des bactéries qui façonnent des cristaux avec du CO2

Biodiversité microbienne Une équipe du BIAM vient de révéler la diversité des bactéries fabriquant des minéraux composés de carbonate de calcium à l’intérieur de leurs cellules. Cette découverte pourrait inspirer des solutions innovantes pour la capture du carbone ou la préservation des écosystèmes face au changement climatique, tout en nous invitant à repenser l’importance de […]